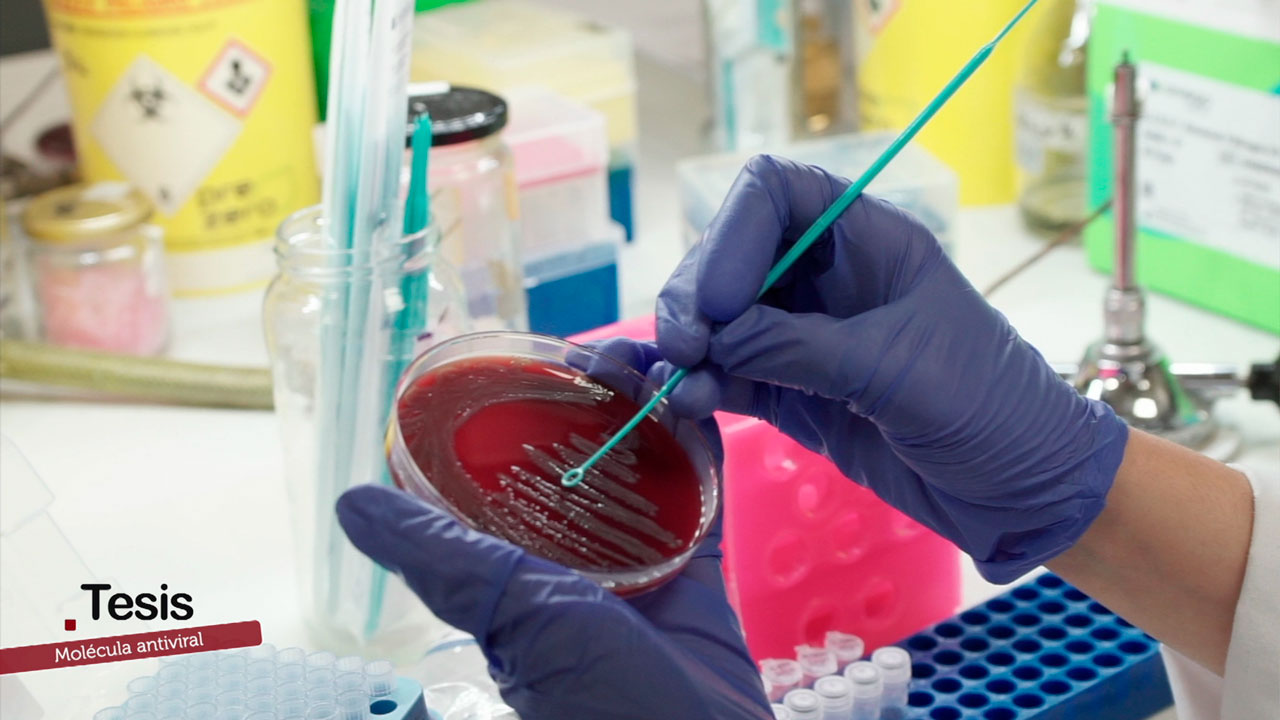
Molécula antiviral que muestra eficacia frente a adenovirus y citomegalovirus

Molécula antiviral: el avance molecular que abre nuevas vías contra los virus
Un equipo de investigación del Instituto de Biomedicina de Sevilla (IBiS), en colaboración con la University of Texas Medical Branch (UTMB), ha desarrollado una nueva molécula antiviral con resultados prometedores frente a adenovirus y citomegalovirus, tanto en pruebas de laboratorio como en modelos animales.
El compuesto, denominado JMX0312, ha sido seleccionado tras varias rondas de optimización por su alta eficacia antiviral y por presentar propiedades favorables de cara a un posible uso terapéutico. La investigación se inició en 2016 ante la escasez de tratamientos eficaces para muchas infecciones virales, especialmente aquellas que afectan a personas con el sistema inmunitario debilitado.
El adenovirus, responsable de infecciones respiratorias, oculares y sistémicas que pueden llegar a ser graves, carece aún de un tratamiento específico aprobado, lo que refuerza la relevancia de este avance. En el caso del citomegalovirus, se estima que alrededor del 50 % de la población ha pasado la infección en algún momento de su vida, lo que lo convierte en un patógeno de gran impacto sanitario.
La evaluación preclínica de la molécula ha contado con la participación clave de la María E. Pachón, investigadora con amplia experiencia en estudios in vivo de compuestos antimicrobianos. Además, los trabajos más recientes indican que JMX0312 también muestra actividad frente a virus de ARN, lo que amplía su potencial aplicación en futuras terapias antivirales.
Tesis se emite el SÁBADO 7/FEB/2026 alrededor de las 20:00 h. en ATV (Andalucía Televisión). Repeticiones en ATV, el DOMINGO 8/FEB a las 11:30 h. y el VIERNES 13/FEB a las 12:30 horas.